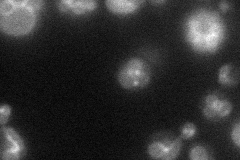
YNL326C
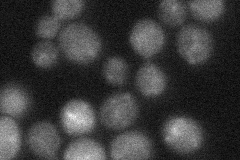
YNL326C
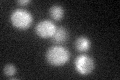
YNL326C
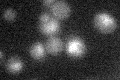
YNL326C

View description
Palmitoyltransferase for Vac8p, required for vacuolar membrane fusion; contains an Asp-His-His-Cys-cysteine rich (DHHC-CRD) domain; autoacylates; required for vacuolar integrity under stress conditions
Localization:
Intensity:
Fold change:
Significance:
-
C’ GFP library in SD

below threshold18.92 -
N' NOP1pr-GFP in SD
vacuole membrane45.9588 -
N' TEF2pr-mCherry in SD

vacuole52.1603 -
N' NATIVEpr-GFP in SD
below threshold21.5247 -
N' TEF2pr-VC and Cyto-VN in SD

below threshold25.6073 -
C’ GFP library in SD+DTT
cytosol17.880.94No -
C’ GFP library in SD+H2O2

cytosol18.850.99No -
C’ GFP library in Starvation Media
cytosol18.440.97No -
C’ GFP library on the background of Pup2-DaMP

N/A -
C’ GFP library on the background of CCT mutant

N/A0N/AYes
